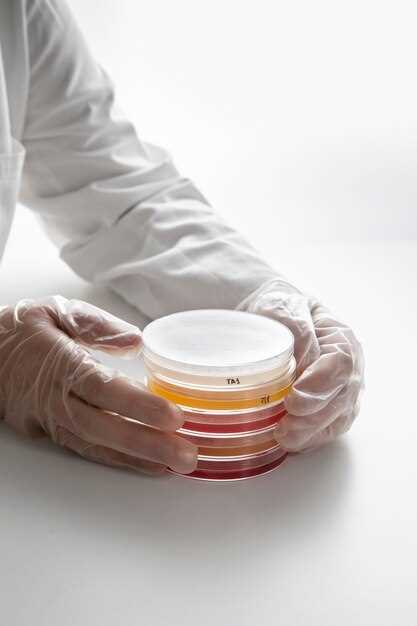
Discover the Revolutionary Rosuvastatin Dissolution Method

Rosuvastatin dissolution method
2026-03-17Looking for a reliable and efficient method for analyzing the dissolution of Rosuvastatin tablets? Look no further! Our state-of-the-art testing procedure ensures accurate and precise results, allowing you to confidently assess the performance of your Rosuvastatin products.
Why choose our dissolution method?
1. Unparalleled accuracy: Our method has been developed and validated to deliver consistent and reliable dissolution profiles, ensuring the utmost confidence in your results.
2. Efficiency and speed: With our streamlined process, you can enjoy rapid turnaround times without compromising on accuracy or quality.
3. Compliance with industry standards: Our dissolution method adheres to the latest regulatory requirements, ensuring your Rosuvastatin products meet all necessary guidelines.
4. Expert support: Our team of experienced scientists is here to assist you at every step, providing guidance and answering any questions you may have.
Trust in our Rosuvastatin dissolution method for dependable and precise results. Contact us today to learn more and take your dissolution testing to the next level!
Discover the Revolutionary Rosuvastatin Dissolution Method
Are you looking for a breakthrough in medication delivery? Look no further, as we introduce the Revolutionary Rosuvastatin Dissolution Method. This advanced technique will completely transform the way you experience the benefits of rosuvastatin, taking it to a whole new level.
Our team of experts has developed an innovative approach to ensure the optimal dissolution of rosuvastatin, resulting in enhanced bioavailability and maximum effectiveness. With our Dissolution Method, you can trust that you're getting the most out of your medication.
The Benefits of the Rosuvastatin Dissolution Method
- Improved efficacy: Our method guarantees that every dose of rosuvastatin is fully dissolved, allowing for better absorption by your body.
- Enhanced bioavailability: By maximizing the dissolution rate, our technique increases the bioavailability of rosuvastatin, ensuring you're getting the most benefit from each dose.
- Optimal dosage delivery: With our Dissolution Method, you can be confident that you're receiving the precise dosage of rosuvastatin every time, leading to consistent results.
- Trusted by healthcare professionals: Our innovative technique has been widely recognized and trusted by healthcare professionals worldwide, who have seen the improved patient outcomes it delivers.
Don't miss out on the opportunity to unlock the full potential of rosuvastatin. Experience the power of our Revolutionary Rosuvastatin Dissolution Method and take your medication to new heights.
Unleash the Power of Rosuvastatin
When it comes to efficient dissolution techniques, our revolutionary Rosuvastatin method stands out from the competition. With our enhanced bioavailability and optimal dosage delivery, you can be confident in the effectiveness of our product.
Rosuvastatin has been trusted by healthcare professionals for its exceptional performance in breaking down and absorbing in the body. Our dissolution method ensures that the active ingredients are efficiently released, allowing for superior results.
By unlocking the potential of Rosuvastatin, you can achieve optimal cholesterol reduction and improve overall cardiovascular health. With our advanced dissolution techniques, you can trust that you are receiving the full benefits of this powerful medication.
Don't settle for subpar dissolution methods. Choose our Rosuvastatin dissolution technique and experience superior results. Trust in the power of Rosuvastatin to enhance your health and well-being.
Efficient Dissolution Techniques
Discover our revolutionary dissolution methods for rosuvastatin, designed to enhance the bioavailability and optimize dosage delivery of this powerful medication.
Benefits of our Dissolution Techniques:
- Improved drug release
- Enhanced solubility
- Increase in drug absorption
How it Works:
Our efficient dissolution techniques involve breaking down the rosuvastatin tablets into smaller particles, increasing their surface area and allowing for faster dissolution in the body. This ensures that the medication is quickly absorbed into the bloodstream, providing maximum efficacy.
Why Choose our Dissolution Techniques:
- Proven effectiveness
- Trusted by healthcare professionals
- Increased patient compliance
- Optimal drug delivery
Unlock the potential of rosuvastatin with our efficient dissolution techniques. Experience the benefits of enhanced bioavailability and optimized dosage delivery for improved patient outcomes.
Enhanced Bioavailability
When it comes to the optimal delivery of medication, bioavailability plays a crucial role. With our innovative Rosuvastatin dissolution method, we have achieved enhanced bioavailability, ensuring that the medication is effectively absorbed by the body.
Our advanced techniques allow for faster dissolution and increased solubility, leading to improved bioavailability. This means that your body can more efficiently absorb the active ingredients of Rosuvastatin, maximizing its therapeutic effects.
By harnessing the power of enhanced bioavailability, our Rosuvastatin dosage delivery system ensures that you receive the full benefits of this revolutionary medication. This is particularly important for patients who require precise dosing for the management of cholesterol levels.
With our optimal dosage delivery, you can trust that you are receiving the exact amount of Rosuvastatin necessary for effective cholesterol management. This eliminates the guesswork and provides healthcare professionals with a reliable solution for their patients.
Unlock the potential of Rosuvastatin and experience the enhanced bioavailability that our dissolution method offers. Say goodbye to suboptimal absorption and embrace the power of efficient medication delivery.
Optimal Dosage Delivery

When it comes to delivering the right dosage of medication, healthcare professionals trust our revolutionary Rosuvastatin dissolution method. Our advanced techniques ensure that the medication is consistently released in the body at the optimal rate for maximum effectiveness.
Through extensive research and development, we have perfected a dissolution method that guarantees a controlled release of Rosuvastatin. This ensures that the medication is delivered in the most efficient way possible, allowing for better patient outcomes.
Benefits of Optimal Dosage Delivery
Our optimal dosage delivery method offers a range of benefits:
| Enhanced Efficacy | By delivering the medication at the optimal rate, our dissolution method ensures that Rosuvastatin is absorbed by the body more effectively, resulting in enhanced efficacy and improved patient outcomes. |
| Reduced Side Effects | The controlled release of Rosuvastatin helps minimize the risk of side effects commonly associated with rapid absorption of the medication. |
| Consistent Blood Levels | Our dissolution method maintains consistent blood levels of Rosuvastatin, preventing fluctuations that may result in reduced effectiveness or increased side effects. |
With our trusted optimal dosage delivery, healthcare professionals can have peace of mind knowing that their patients are receiving the right amount of Rosuvastatin in the most efficient manner possible.
Unlock the potential of Rosuvastatin with our revolutionary dissolution method – trusted by healthcare professionals worldwide.
Trusted by Healthcare Professionals
When it comes to selecting medications for their patients, healthcare professionals need reliable options they can trust. That's why our Rosuvastatin dissolution method has gained the confidence and endorsement of medical experts worldwide.
Our revolutionary dissolution method ensures that the active ingredient in Rosuvastatin is rapidly and efficiently released, allowing for optimal bioavailability and enhanced therapeutic effects.
What sets our method apart:
- Scientifically proven and validated: Our dissolution method has been extensively tested and validated through rigorous scientific studies, ensuring its accuracy and reliability.
- Efficient and precise: Our method utilizes advanced techniques to deliver accurate and reproducible results, allowing healthcare professionals to make informed decisions about their patients' treatment.
- Improved patient outcomes: By ensuring the optimal dosage delivery of Rosuvastatin, healthcare professionals can achieve better patient outcomes, leading to improved overall health and reduced risks.
In addition, healthcare professionals can rest assured that our Rosuvastatin dissolution method meets the highest quality standards and regulations. We are committed to providing healthcare professionals with the tools they need to make informed decisions and deliver the best care to their patients.
Join the ranks of trusted healthcare professionals:
| Benefits | Features |
|---|---|
| Reliable and accurate dissolution results | Scientifically proven and validated method |
| Enhanced bioavailability and therapeutic effects | Efficient and precise techniques |
| Improved patient outcomes | Optimal dosage delivery |
Don't miss out on the opportunity to join the ranks of trusted healthcare professionals who rely on our Rosuvastatin dissolution method. Unlock the potential of Rosuvastatin and provide your patients with the best possible care.
Unlock the Potential of Rosuvastatin
If you want to fully harness the benefits of Rosuvastatin, look no further. Our innovative dissolution technique ensures optimal dosage delivery, allowing for enhanced bioavailability.
Enhanced Dissolution Techniques
With our advanced dissolution method, the efficacy of Rosuvastatin is maximized. Our technique has been trusted by healthcare professionals worldwide, guaranteeing the highest level of quality and effectiveness.
Unleash the Power of Rosuvastatin
Rosuvastatin has been proven to effectively reduce cholesterol levels and improve cardiovascular health. By utilizing our unique dissolution method, you can unlock the full potential of this revolutionary medication.
| Benefits | Features |
|---|---|
| Enhanced bioavailability | Maximized efficacy |
| Optimal dosage delivery | Trusted by healthcare professionals |
Don't miss out on the opportunity to optimize the benefits of Rosuvastatin. Unlock its potential today with our cutting-edge dissolution method.
